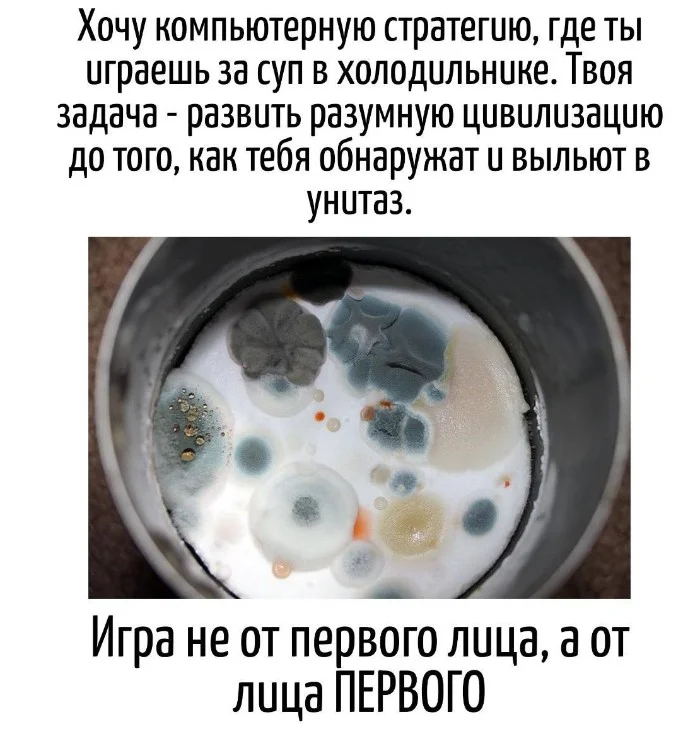

Игра слов – это смешно, остроумно и неожиданно. Фразы, каламбуры и шутки, которые заставляют задуматься и смеяться одновременно. Погружаемся в мир лингвистического юмора и находим юмор там, где его меньше всего ожидаешь.










Игра слов – это смешно, остроумно и неожиданно. Фразы, каламбуры и шутки, которые заставляют задуматься и смеяться одновременно. Погружаемся в мир лингвистического юмора и находим юмор там, где его меньше всего ожидаешь.